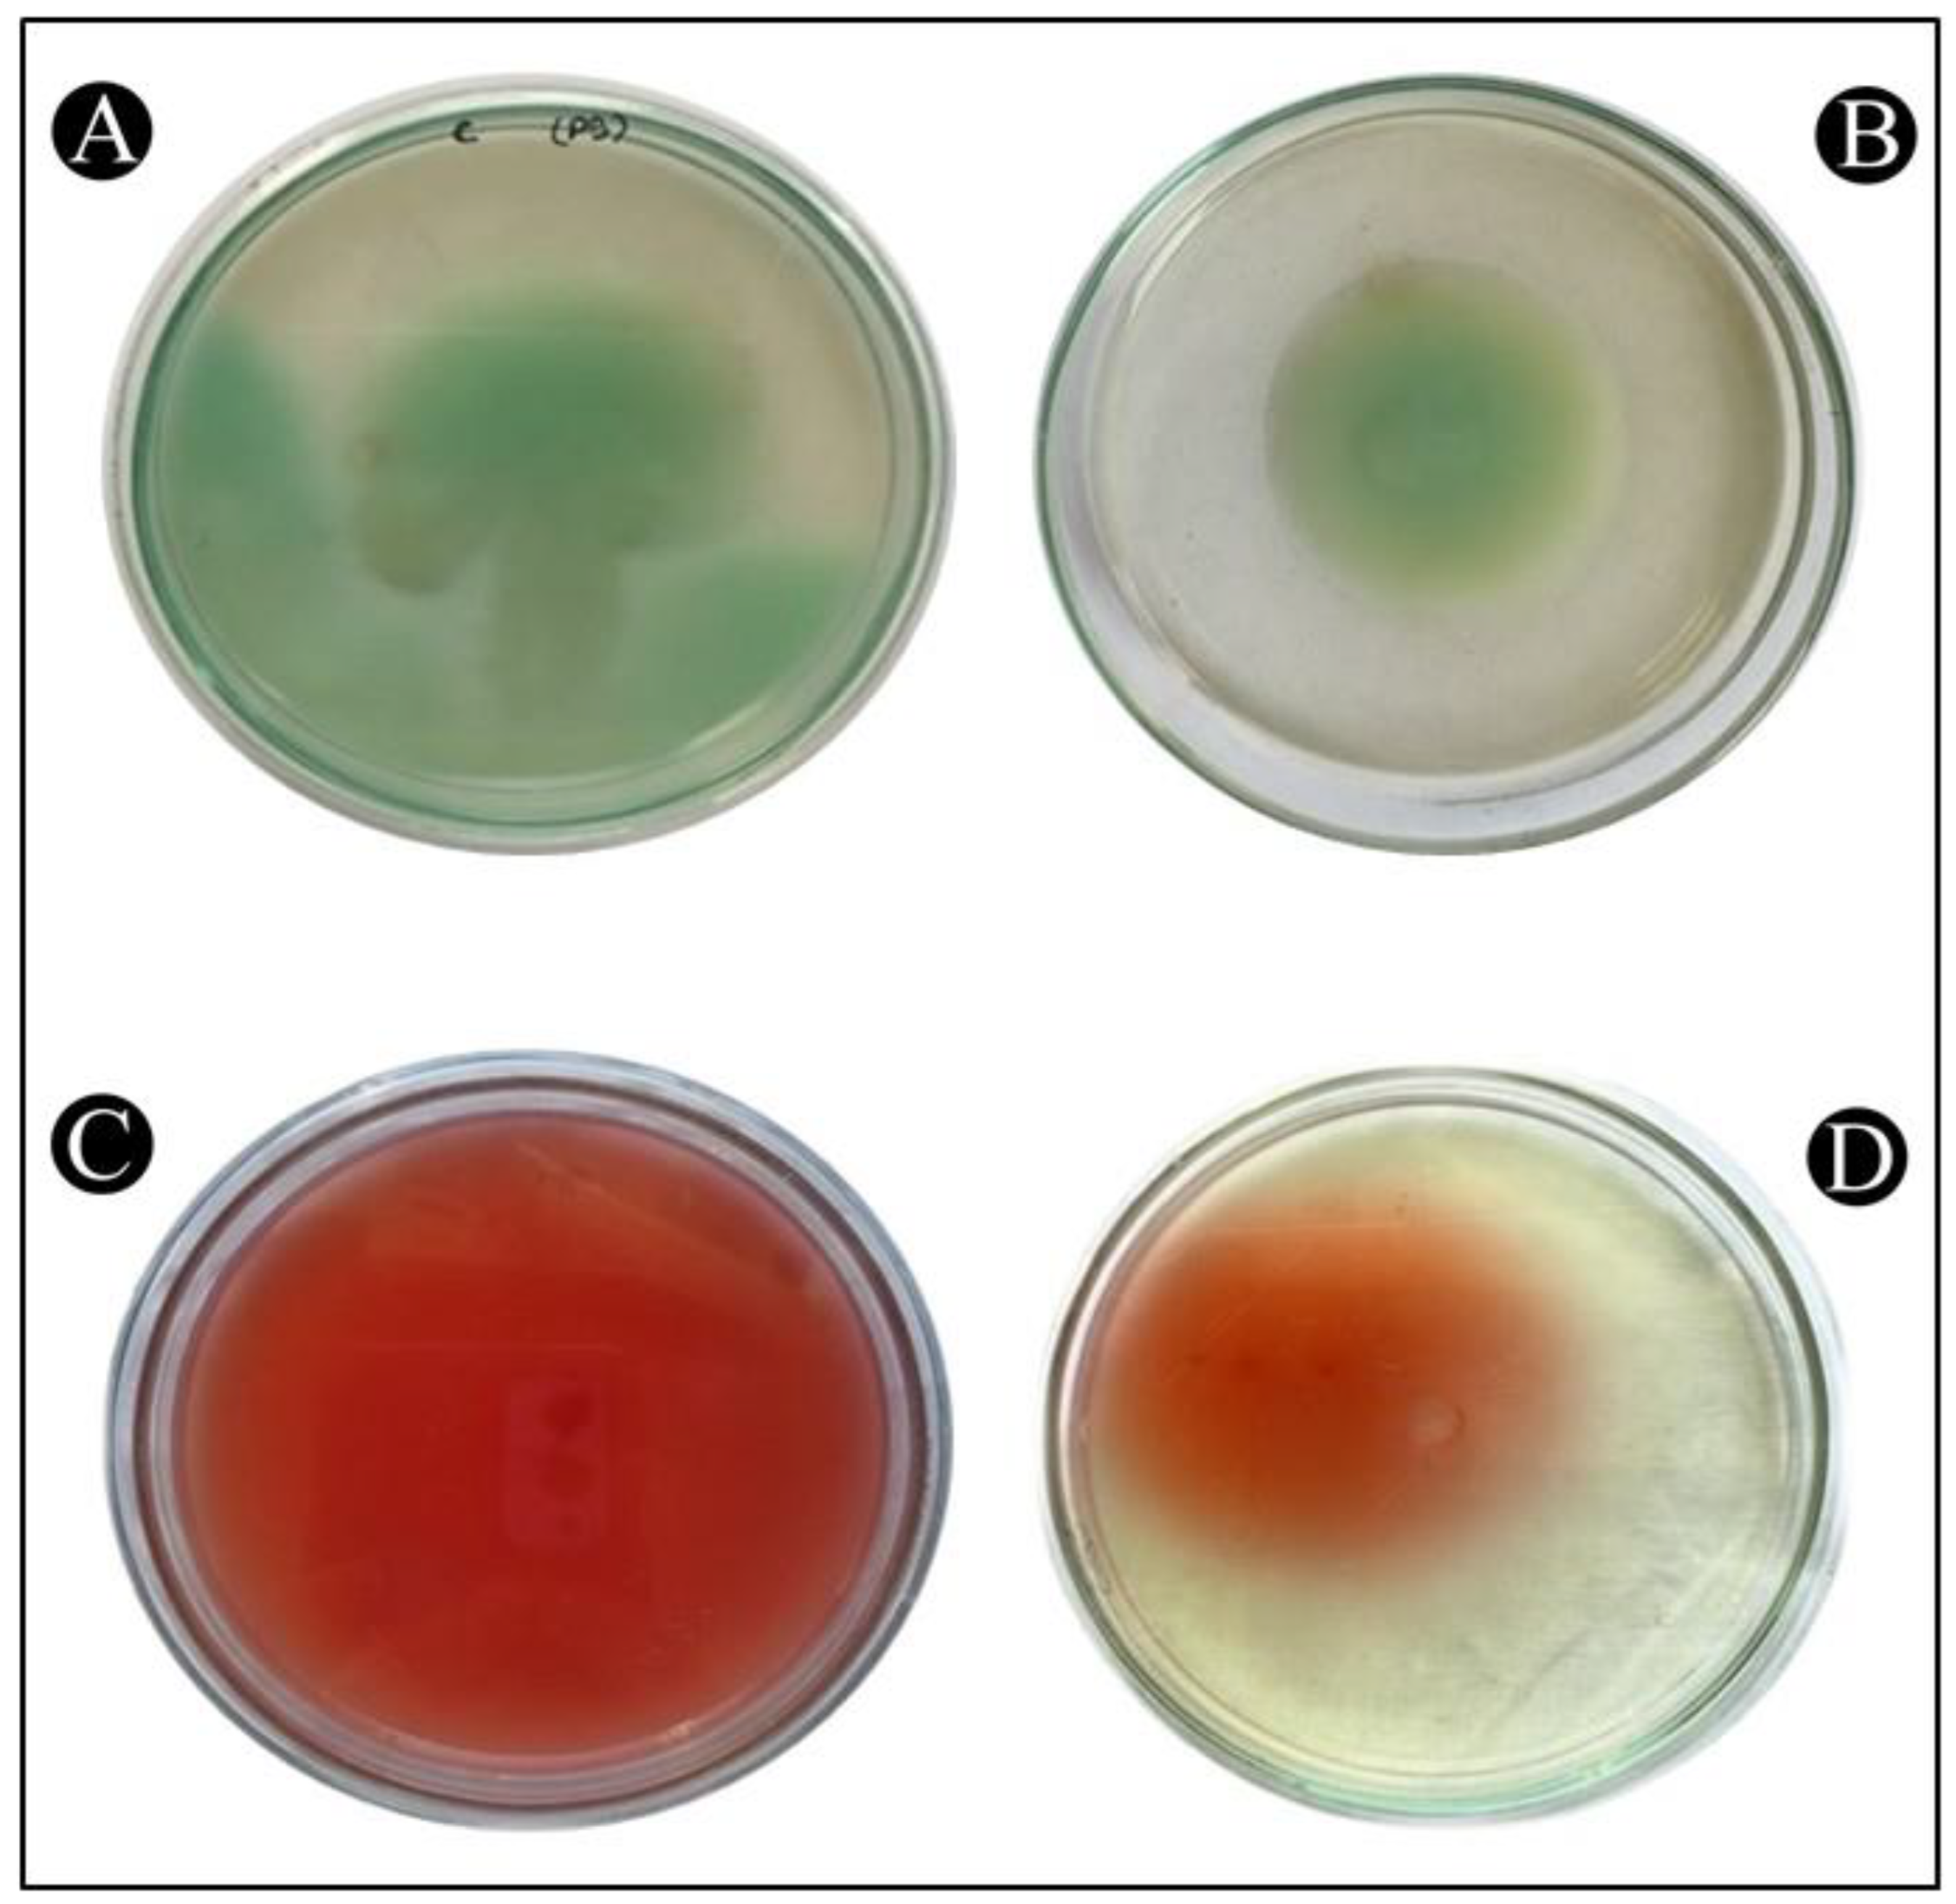
Antibiotics 12 00986 g009

Biosynthesized Silver Nanoparticles Derived from Probiotic Lactobacillus rhamnosus (AgNPs-LR) Targeting Biofilm Formation and Quorum Sensing-Mediated Virulence Factors
Abstract
:1. Introduction
2. Materials and Methods
2.1. Strains of Bacteria and Growth Conditions
2.2. Biosynthesis of Silver Nanoparticles (AgNPs) Using L. rhamnosus (AgNPs-LR)
2.3. Characterization of AgNPs-LR
2.3.1. Ultraviolet-Vis Analysis
2.3.2. FTIR Analysis
2.3.3. Transmission Electron Microscopy (TEM)
2.4. Antibacterial Activity of AgNPs-LA
2.5. Determination of Minimum Inhibitory Concentration (MIC)
2.6. Assessment of the Quantity of Violacein Pigment in C. violaceum
2.7. Assessment of the Quantity of Prodigiosin Pigment in S. marcescens
2.8. Assessment of QS-Mediated Virulence Factors of P. aeruginosa
2.8.1. Estimation of Pyocyanin
2.8.2. Assessment of Pyoverdine
2.8.3. Assessment of LasA Staphylolytic Assay
2.8.4. Assessment of LasB Elastinolytic Activity
2.8.5. Assessment of Rhamnolipid
2.9. Determination of the Swimming Motility of P. aeruginosa and S. marcescens
2.10. Assessment of Antibiofilm Activity
2.11. Light Microscopic Assessment of Biofilm Inhibition
2.12. Assessment of Exopolysaccharide (EPS) Production
3. Results
3.1. Synthesis and Characterization of AgNPs-LR
3.2. Antibacterial Potential of Biosynthesized AgNPs-LR
3.3. Inhibition of Inhibition of Virulence Factors of C. violaceum
3.4. Inhibition of Virulence Factors of S. marcescens
3.5. Inhibition of Virulence Factors of P. aeruginosa
3.6. Quantitative Inhibition of the Formation of Biofilms
3.7. Inhibition of EPS Production
3.8. Analysis of Biofilm Inhibition on Glass Surfaces Using Microscope
3.9. Inhibition of Swimming Motility
4. Discussion
5. Conclusions
Author Contributions
Funding
Institutional Review Board Statement
Informed Consent Statement
Data Availability Statement
Acknowledgments
Conflicts of Interest
References
- Tanwar, J.; Das, S.; Fatima, Z.; Hameed, S. Multidrug Resistance: An Emerging Crisis. Interdiscip. Perspect. Infect. Dis. 2014, 2014, 541340. [Google Scholar] [CrossRef]
- Aslam, B.; Wang, W.; Arshad, M.I.; Khurshid, M.; Muzammil, S.; Rasool, M.H.; Nisar, M.A.; Alvi, R.F.; Aslam, M.A.; Qamar, M.U. Antibiotic Resistance: A Rundown of a Global Crisis. Infect. Drug Resist. 2018, 11, 1645. [Google Scholar] [CrossRef] [PubMed]
- Sabtu, N.; Enoch, D.A.; Brown, N.M. Antibiotic Resistance: What, Why, Where, When and How? Br. Med. Bull. 2015, 116, 105–113. [Google Scholar] [CrossRef]
- Murray, C.J.L.; Ikuta, K.S.; Sharara, F.; Swetschinski, L.; Aguilar, G.R.; Gray, A.; Han, C.; Bisignano, C.; Rao, P.; Wool, E.; et al. Global Burden of Bacterial Antimicrobial Resistance in 2019: A Systematic Analysis. Lancet 2022, 399, 629–655. [Google Scholar] [CrossRef]
- Dadgostar, P. Antimicrobial Resistance: Implications and Costs. Infect. Drug Resist. 2019, 12, 3903–3910. [Google Scholar] [CrossRef]
- Giurazza, R.; Mazza, M.C.; Andini, R.; Sansone, P.; Pace, M.C.; Durante-Mangoni, E. Emerging Treatment Options for Multi-Drug-Resistant Bacterial Infections. Life 2021, 11, 519. [Google Scholar] [CrossRef] [PubMed]
- Roca, I.; Akova, M.; Baquero, F.; Carlet, J.; Cavaleri, M.; Coenen, S.; Cohen, J.; Findlay, D.; Gyssens, I.; Heure, O.E. The Global Threat of Antimicrobial Resistance: Science for Intervention. New Microbes New Infect. 2015, 6, 22–29. [Google Scholar] [CrossRef]
- World Health Organization. Global Antimicrobial Resistance and Use Surveillance System (GLASS) Report: 2021; World Health Organization: Geneva, Switzerland, 2021.
- Mshana, S.E.; Sindato, C.; Matee, M.I.; Mboera, L.E.G. Antimicrobial Use and Resistance in Agriculture and Food Production Systems in Africa: A Systematic Review. Antibiotics 2021, 10, 976. [Google Scholar] [CrossRef] [PubMed]
- Majumder, M.A.A.; Rahman, S.; Cohall, D.; Bharatha, A.; Singh, K.; Haque, M.; Gittens-St Hilaire, M. Antimicrobial Stewardship: Fighting Antimicrobial Resistance and Protecting Global Public Health. Infect. Drug Resist. 2020, 13, 4713–4738. [Google Scholar] [CrossRef]
- Ranjalkar, J.; Chandy, S.J. India’s National Action Plan for Antimicrobial Resistance–An Overview of the Context, Status, and Way Ahead. J. Fam. Med. Prim. Care 2019, 8, 1828. [Google Scholar] [CrossRef] [PubMed]
- Sharma, P.; Towse, A. New Drugs to Tackle Antimicrobial Resistance: Analysis of EU Policy Options. Available SSRN 2640028. 2010. Available online: https://www.ohe.org/publications/new-drugs-tackle-antimicrobial-resistance-analysis-eu-policy-options/ (accessed on 4 April 2023).
- Piewngam, P.; Chiou, J.; Chatterjee, P.; Otto, M. Alternative Approaches to Treat Bacterial Infections: Targeting Quorum-Sensing. Expert Rev. Anti. Infect. Ther. 2020, 18, 499–510. [Google Scholar] [CrossRef]
- Davies, D.G.; Parsek, M.R.; Pearson, J.P.; Iglewski, B.H.; Costerton, J.W.; Greenberg, E.P. The Involvement of Cell-to-Cell Signals in the Development of a Bacterial Biofilm. Science 1998, 280, 295–298. [Google Scholar] [CrossRef] [PubMed]
- López, D.; Vlamakis, H.; Kolter, R. Biofilms. Cold Spring Harb. Perspect. Biol. 2010, 2, a000398. [Google Scholar] [CrossRef] [PubMed]
- Donlan, R.M. Biofilm Formation: A Clinically Relevant Microbiological Process. Clin. Infect. Dis. 2001, 33, 1387–1392. [Google Scholar] [CrossRef]
- Schachter, B. Slimy Business—The Biotechnology of Biofilms. Nat. Biotechnol. 2003, 21, 361–365. [Google Scholar] [CrossRef]
- Martins, N.; Rodrigues, C.F. Biomaterial-Related Infections. J. Clin. Med. 2020, 9, 722. [Google Scholar] [CrossRef] [PubMed]
- Lasa, I.; Del Pozo, J.L.; Penadés, J.R.; Leiva, J. Biofilms Bacterianos e Infección. In Anales del Sistema Sanitario de Navarra; Gobierno de Navarra. Departamento de Salud: Pamplona, Spain, 2005; Volume 28, pp. 163–175. [Google Scholar]
- Qais, F.A.; Khan, M.S.; Ahmad, I. Nanoparticles as Quorum Sensing Inhibitor: Prospects and Limitations. In Biotechnological Applications of Quorum Sensing Inhibitors; Springer: Berlin/Heidelberg, Germany, 2018; pp. 227–244. [Google Scholar]
- Nagajyothi, P.C.; Cha, S.J.; Yang, I.J.; Sreekanth, T.V.M.; Kim, K.J.; Shin, H.M. Antioxidant and Anti-Inflammatory Activities of Zinc Oxide Nanoparticles Synthesized Using Polygala Tenuifolia Root Extract. J. Photochem. Photobiol. B Biol. 2015, 146, 10–17. [Google Scholar] [CrossRef]
- Manikandan, R.; Manikandan, B.; Raman, T.; Arunagirinathan, K.; Prabhu, N.M.; Basu, M.J.; Perumal, M.; Palanisamy, S.; Munusamy, A. Biosynthesis of Silver Nanoparticles Using Ethanolic Petals Extract of Rosa Indica and Characterization of Its Antibacterial, Anticancer and Anti-Inflammatory Activities. Spectrochim. Acta Part A Mol. Biomol. Spectrosc. 2015, 138, 120–129. [Google Scholar] [CrossRef]
- Mohanpuria, P.; Rana, N.K.; Yadav, S.K. Biosynthesis of Nanoparticles: Technological Concepts and Future Applications. J. Nanoparticle Res. 2008, 10, 507–517. [Google Scholar] [CrossRef]
- Sre, P.R.R.; Reka, M.; Poovazhagi, R.; Kumar, M.A.; Murugesan, K. Antibacterial and Cytotoxic Effect of Biologically Synthesized Silver Nanoparticles Using Aqueous Root Extract of Erythrina Indica Lam. Spectrochim. Acta Part A Mol. Biomol. Spectrosc. 2015, 135, 1137–1144. [Google Scholar]
- Nishiyama, K.; Sugiyama, M.; Mukai, T. Adhesion properties of lactic acid bacteria on intestinal mucin. Microorganisms 2016, 4, 34. [Google Scholar] [CrossRef]
- Zhang, C.; Gui, Y.; Chen, X.; Chen, D.; Guan, C.; Yin, B.; Pan, Z.; Gu, R. Transcriptional homogenization of Lactobacillus rhamnosus hsryfm 1301 under heat stress and oxidative stress. Appl. Microbiol. Biotechnol. 2020, 104, 2611–2621. [Google Scholar] [CrossRef]
- Matsubara, V.H.; Wang, Y.; Bandara, H.M.H.N.; Mayer, M.P.A.; Samaranayake, L.P. Probiotic lactobacilli inhibit early stages of Candida albicans biofilm development by reducing their growth, cell adhesion, and filamentation. Appl. Microbiol. Biotechnol. 2016, 100, 6415–6426. [Google Scholar] [CrossRef] [PubMed]
- Li, N.; Pang, B.; Li, J.; Liu, G.; Xu, X.; Shao, D.; Jiang, C.; Yang, B.; Shi, J. Mechanisms for Lactobacillus rhamnosus treatment of intestinal infection by drug-resistant Escherichia coli. Food Funct. 2020, 11, 4428–4445. [Google Scholar] [CrossRef]
- Zhang, W.; Zhu, Y.H.; Yang, G.Y.; Liu, X.; Xia, B.; Hu, X.; Su, J.H.; Wang, J.F. Lactobacillus rhamnosus GG affects microbiota and suppresses autophagy in the intestines of pigs challenged with Salmonella Infantis. Front. Microbiol. 2018, 8, 2705. [Google Scholar] [CrossRef]
- Assaf, J.C.; Khoury, A.E.; Chokr, A.; Louka, N.; Atoui, A. A novel method for elimination of aflatoxin M1 in milk using Lactobacillus rhamnosus GG biofilm. Int. J. Dairy Technol. 2019, 72, 248–256. [Google Scholar] [CrossRef]
- Syame, S.M.; Mansour, A.S.; Khalaf, D.D.; Ibrahim, E.S.; Gaber, E.S. Green Synthesis of Silver Nanoparticles Using Lactic Acid Bacteria: Assessment of Antimicrobial Activity. World’s Vet. J. 2020, 10, 625–633. [Google Scholar] [CrossRef]
- Haiss, W.; Thanh, N.T.; Aveyard, J.; Fernig, D.G. Determination of size and concentration of gold nanoparticles from UV−Vis spectra. Anal. Chem. 2007, 79, 4215–4221. [Google Scholar] [CrossRef] [PubMed]
- Adebayo-Tayo, B.C.; Popoola, A.O. Biogenic Synthesis and Antimicrobial Activity of Silver Nanoparticle Using Exopolysaccharides from Lactic Acid Bacteria. Int. J. Nano Dimens. 2017, 8, 61. [Google Scholar]
- Sintubin, L.; De Windt, W.; Dick, J.; Mast, J.; Van Der Ha, D.; Verstraete, W.; Boon, N. Lactic Acid Bacteria as Reducing and Capping Agent for the Fast and Efficient Production of Silver Nanoparticles. Appl. Microbiol. Biotechnol. 2009, 84, 741–749. [Google Scholar] [CrossRef]
- Shameli, K.; Ahmad, M.B.; Yunus, W.M.Z.W.; Ibrahim, N.A.; Rahman, R.A.; Jokar, M.; Darroudi, M. Silver/Poly (Lactic Acid) Nanocomposites: Preparation, Characterization, and Antibacterial Activity. Int. J. Nanomed. 2010, 7, 573–579. [Google Scholar] [CrossRef] [PubMed]
- Biedenbach, D.; Lob, S.; Badal, R.; Sahm, D. Variability of Susceptibility and Multidrug Resistance among K. pneumoniae from IAI in Asia/Pacific Countries–SMART 2012–2013. Int. J. Antimicrob. Agents PO BOX 2015, 211, 1000. [Google Scholar]
- Matz, C.; Deines, P.; Boenigk, J.; Arndt, H.; Eberl, L.; Kjelleberg, S.; Jürgens, K. Impact of Violacein-Producing Bacteria on Survival and Feeding of Bacterivorous Nanoflagellates. Appl. Environ. Microbiol. 2004, 70, 1593–1599. [Google Scholar] [CrossRef] [PubMed]
- Slater, H.; Crow, M.; Everson, L.; Salmond, G.P.C. Phosphate Availability Regulates Biosynthesis of Two Antibiotics, Prodigiosin and Carbapenem, in Serratia via Both Quorum-sensing-dependent And-independent Pathways. Mol. Microbiol. 2003, 47, 303–320. [Google Scholar] [CrossRef]
- Essar, D.W.; Eberly, L.E.E.; Hadero, A.; Crawford, I.P. Identification and Characterization of Genes for a Second Anthranilate Synthase in Pseudomonas aeruginosa: Interchangeability of the Two Anthranilate Synthases and Evolutionary Implications. J. Bacteriol. 1990, 172, 884–900. [Google Scholar] [CrossRef] [PubMed]
- Ankenbauer, R.; Sriyosachati, S.; Cox, C.D. Effects of Siderophores on the Growth of Pseudomonas aeruginosa in Human Serum and Transferrin. Infect. Immun. 1985, 49, 132–140. [Google Scholar] [CrossRef]
- Kessler, E.; Safrin, M.; Olson, J.C.; Ohman, D.E. Secreted LasA of Pseudomonas aeruginosa is a Staphylolytic Protease. J. Biol. Chem. 1993, 268, 7503–7508. [Google Scholar] [CrossRef]
- Adonizio, A.; Kong, K.-F.; Mathee, K. Inhibition of Quorum Sensing-Controlled Virulence Factor Production in Pseudomonas aeruginosa by South Florida Plant Extracts. Antimicrob. Agents Chemother. 2008, 52, 198–203. [Google Scholar] [CrossRef]
- Pinzon, N.M.; Ju, L.-K. Analysis of Rhamnolipid Biosurfactants by Methylene Blue Complexation. Appl. Microbiol. Biotechnol. 2009, 82, 975–981. [Google Scholar] [CrossRef]
- Kumar, L.; Chhibber, S.; Harjai, K. Zingerone Inhibit Biofilm Formation and Improve Antibiofilm Efficacy of Ciprofloxacin against Pseudomonas aeruginosa PAO1. Fitoterapia 2013, 90, 73–78. [Google Scholar] [CrossRef]
- Ghaima, K.K.; Rasheed, S.F.; Ahmed, E.F. Antibiofilm, Antibacterial and Antioxidant Activities of Water Extract of Calendula officinalis Flowers. Int. J. Biol. Pharm. Res. 2013, 4, 465–470. [Google Scholar]
- Musthafa, K.S.; Ravi, A.V.; Annapoorani, A.; Packiavathy, I.S.V.; Pandian, S.K. Evaluation of Anti-Quorum-Sensing Activity of Edible Plants and Fruits through Inhibition of the N-Acyl-Homoserine Lactone System in Chromobacterium violaceum and Pseudomonas aeruginosa. Chemotherapy 2010, 56, 333–339. [Google Scholar] [CrossRef] [PubMed]
- Borucki, M.K.; Krug, M.J.; Muraoka, W.T.; Call, D.R. Discrimination among Listeria monocytogenes Isolates Using a Mixed Genome DNA Microarray. Vet. Microbiol. 2003, 92, 351–362. [Google Scholar] [CrossRef] [PubMed]
- Guandalini, S. Probiotics for Prevention and Treatment of Diarrhea. J. Clin. Gastroenterol. 2011, 45, S149–S153. [Google Scholar] [CrossRef]
- Ahmed, S.; Ikram, S. Silver Nanoparticles: One Pot Green Synthesis Using Terminalia arjuna Extract for Biological Application. J. Nanomed. Nanotechnol. 2015, 6, 309. [Google Scholar]
- Tsuji, T.; Iryo, K.; Watanabe, N.; Tsuji, M. Preparation of silver nanoparticles by laser ablation in solution: Influence of laser wavelength on particle size. Appl. Surface Sci. 2002, 202, 80–85. [Google Scholar] [CrossRef]
- Murphy, C.J.; Jana, N.R. Controlling the aspect ratio of inorganic nanorods and nanowires. Adv. Mat. 2002, 14, 80–82. [Google Scholar] [CrossRef]
- Sastry, M.; Mayya, K.S.; Bandyopadhyay, K. pH Dependent changes in the optical properties of carboxylic acid derivatized silver colloidal particles. Colloids Surf. A Physicochem. Eng. Asp. 1997, 127, 221–228. [Google Scholar] [CrossRef]
- Sondi, I.; Goia, D.V.; Matijević, E. Preparation of Highly Concentrated Stable Dispersions of Uniform Silver Nanoparticles. J. Colloid Interface Sci. 2003, 260, 75–81. [Google Scholar] [CrossRef]
- Torabiana, P.; Ghandeharia, F.; Fatemib, M. Asian Journal of Green Chemistry. Asian J. Green. Chem. 2017, 2, 89–97. [Google Scholar]
- Rajesh, S.; Dharanishanthi, V.; Kanna, A.V. Antibacterial Mechanism of Biogenic Silver Nanoparticles of Lactobacillus acidophilus. J. Exp. Nanosci. 2015, 10, 1143–1152. [Google Scholar] [CrossRef]
- Nithya, R.; Ragunathan, R. Synthesis of Silver Nanoparticles Using a Probiotic Microbe and Its Antibacterial Effect against Multidrug Resistant Bacteria. Afr. J. Biotechnol. 2012, 11, 11013–11021. [Google Scholar]
- Xu, C.; Guo, Y.; Qiao, L.; Ma, L.; Cheng, Y.; Roman, A. Biogenic Synthesis of Novel Functionalized Selenium Nanoparticles by Lactobacillus Casei ATCC 393 and Its Protective Effects on Intestinal Barrier Dysfunction Caused by Enterotoxigenic Escherichia coli K88. Front. Microbiol. 2018, 9, 1129. [Google Scholar] [CrossRef] [PubMed]
- Markus, J.; Mathiyalagan, R.; Kim, Y.-J.; Abbai, R.; Singh, P.; Ahn, S.; Perez, Z.E.J.; Hurh, J.; Yang, D.C. Intracellular Synthesis of Gold Nanoparticles with Antioxidant Activity by Probiotic Lactobacillus kimchicus DCY51T Isolated from Korean Kimchi. Enzym. Microb. Technol. 2016, 95, 85–93. [Google Scholar] [CrossRef] [PubMed]
- Kumar, K.K.; Mahalakshmi, S.; Harikrishna, N.; Reddy, G. Production, characterization and antimicrobial activity of silver nanoparticles produced by Lactobacillus amylophilus GV6. European J. Pharm. Med. Res. 2016, 3, 236242. [Google Scholar]
- Garmasheva, I.; Kovalenko, N.; Voychuk, S.; Ostapchuk, A.; Livins’ka, O.; Oleschenko, L. Lactobacillus species mediated synthesis of silver nanoparticles and their antibacterial activity against opportunistic pathogens in vitro. BioImpacts BI 2016, 6, 219. [Google Scholar] [CrossRef]
- Naseer, Q.A.; Xue, X.; Wang, X.; Dang, S.; Din, S.U.; Jamil, J. Synthesis of silver nanoparticles using Lactobacillus bulgaricus and assessment of their antibacterial potential. Braz. J. Biol. 2021, 82, e232434. [Google Scholar] [CrossRef]
- Sharma, S.; Sharma, N.; Kaushal, N. Comparative Account of Biogenic Synthesis of Silver Nanoparticles Using Probiotics and Their Antimicrobial Activity Against Challenging Pathogens. BioNanoScience 2022, 12, 833–840. [Google Scholar] [CrossRef]
- Kalaiyarasan, T.; Bharti, V.K.; Chaurasia, O.P. Retracted Article: One Pot Green Preparation of Seabuckthorn Silver Nanoparticles (SBT@ AgNPs) Featuring High Stability and Longevity, Antibacterial, Antioxidant Potential: A Nano Disinfectant Future Perspective. RSC Adv. 2017, 7, 51130–51141. [Google Scholar] [CrossRef]
- Kora, A.J.; Arunachalam, J. Assessment of Antibacterial Activity of Silver Nanoparticles on Pseudomonas aeruginosa and Its Mechanism of Action. World J. Microbiol. Biotechnol. 2011, 27, 1209–1216. [Google Scholar] [CrossRef]
- Otto, M. Staphylococcal Biofilms. In Bacterial Biofilms; Springer: Berlin/Heidelberg, Germany, 2008; pp. 207–228. [Google Scholar]
- Gupta, P.; Chhibber, S.; Harjai, K. Subinhibitory Concentration of Ciprofloxacin Targets Quorum Sensing System of Pseudomonas aeruginosa Causing Inhibition of Biofilm Formation & Reduction of Virulence. Indian J. Med. Res. 2016, 143, 643. [Google Scholar]
- Pompilio, A.; Crocetta, V.; De Nicola, S.; Verginelli, F.; Fiscarelli, E.; Di Bonaventura, G. Cooperative Pathogenicity in Cystic Fibrosis: Stenotrophomonas Maltophilia Modulates Pseudomonas aeruginosa Virulence in Mixed Biofilm. Front. Microbiol. 2015, 6, 951. [Google Scholar] [CrossRef] [PubMed]
- Nickel, J.C.; Ruseska, I.; Wright, J.B.; Costerton, J.W. Tobramycin Resistance of Pseudomonas aeruginosa Cells Growing as a Biofilm on Urinary Catheter Material. Antimicrob. Agents Chemother. 1985, 27, 619–624. [Google Scholar] [CrossRef] [PubMed]
- Ali, K.; Ahmed, B.; Dwivedi, S.; Saquib, Q.; Al-Khedhairy, A.A.; Musarrat, J. Microwave Accelerated Green Synthesis of Stable Silver Nanoparticles with Eucalyptus globulus Leaf Extract and Their Antibacterial and Antibiofilm Activity on Clinical Isolates. PLoS ONE 2015, 10, e0131178. [Google Scholar] [CrossRef]
- Ali, S.G.; Ansari, M.A.; Khan, H.M.; Jalal, M.; Mahdi, A.A.; Cameotra, S.S. Antibacterial and Antibiofilm Potential of Green Synthesized Silver Nanoparticles against Imipenem Resistant Clinical Isolates of P. aeruginosa. Bionanoscience 2018, 8, 544–553. [Google Scholar] [CrossRef]
- Chhibber, S.; Gondil, V.S.; Sharma, S.; Kumar, M.; Wangoo, N.; Sharma, R.K. A Novel Approach for Combating Klebsiella pneumoniae Biofilm Using Histidine Functionalized Silver Nanoparticles. Front. Microbiol. 2017, 8, 1104. [Google Scholar] [CrossRef]
- Miller, M.B.; Bassler, B.L. Quorum Sensing in Bacteria. Annu. Rev. Microbiol. 2001, 55, 165–199. [Google Scholar] [CrossRef]
- Jiang, Q.; Chen, J.; Yang, C.; Yin, Y.; Yao, K. Quorum Sensing: A Prospective Therapeutic Target for Bacterial Diseases. BioMed Res. Int. 2019, 2019, 2015978. [Google Scholar] [CrossRef]
- Gajdács, M.; Spengler, G. The Role of Drug Repurposing in the Development of Novel Antimicrobial Drugs: Non-Antibiotic Pharmacological Agents as Quorum Sensing-Inhibitors. Antibiotics 2019, 8, 270. [Google Scholar] [CrossRef]
- Abraham, W.-R. Controlling Pathogenic Gram-Negative Bacteria by Interfering with Their Biofilm Formation. Drug Des. Rev. 2005, 2, 13–33. [Google Scholar] [CrossRef]
- Vijay, K.; Sakshi, S.; Divya, P. Recent Research Advances on Chromobacterium violaceum. Asian Pac. J. Trop. Med. 2017, 10, 810–818. [Google Scholar]
- Lau, G.W.; Hassett, D.J.; Ran, H.; Kong, F. The Role of Pyocyanin in Pseudomonas aeruginosa Infection. Trends Mol. Med. 2004, 10, 599–606. [Google Scholar] [CrossRef] [PubMed]
- De Vleesschauwer, D.; Cornelis, P.; Höfte, M. Redox-Active Pyocyanin Secreted by Pseudomonas aeruginosa 7NSK2 Triggers Systemic Resistance to Magnaporthe Grisea but Enhances Rhizoctonia solani Susceptibility in Rice. Mol. Plant-Microbe Interact. 2006, 19, 1406–1419. [Google Scholar] [CrossRef] [PubMed]
- Usher, L.R.; Lawson, R.A.; Geary, I.; Taylor, C.J.; Bingle, C.D.; Taylor, G.W.; Whyte, M.K.B. Induction of Neutrophil Apoptosis by the Pseudomonas aeruginosa Exotoxin Pyocyanin: A Potential Mechanism of Persistent Infection. J. Immunol. 2002, 168, 1861–1868. [Google Scholar] [CrossRef] [PubMed]
- Manago, A.; Becker, K.A.; Carpinteiro, A.; Wilker, B.; Soddemann, M.; Seitz, A.P.; Edwards, M.J.; Grassmé, H.; Szabo, I.; Gulbins, E. Pseudomonas aeruginosa Pyocyanin Induces Neutrophil Death via Mitochondrial Reactive Oxygen Species and Mitochondrial Acid Sphingomyelinase. Antioxid. Redox Signal. 2015, 22, 1097–1110. [Google Scholar] [CrossRef]
- Ringel, M.T.; Brüser, T. The Biosynthesis of Pyoverdines. Microb. Cell 2018, 5, 424. [Google Scholar] [CrossRef]
- Meyer, J.-M.; Neely, A.; Stintzi, A.; Georges, C.; Holder, I.A. Pyoverdin Is Essential for Virulence of Pseudomonas aeruginosa. Infect. Immun. 1996, 64, 518–523. [Google Scholar] [CrossRef] [PubMed]
- Coin, D.; Louis, D.; Bernillon, J.; Guinand, M.; Wallach, J. LasA, Alkaline Protease and Elastase in Clinical Strains of Pseudomonas Aeruginosa: Quantification by Immunochemical Methods. FEMS Immunol. Med. Microbiol. 1997, 18, 175–184. [Google Scholar] [CrossRef]
- Casilag, F.; Lorenz, A.; Krueger, J.; Klawonn, F.; Weiss, S.; Häussler, S. The LasB Elastase of Pseudomonas Aeruginosa Acts in Concert with Alkaline Protease AprA to Prevent Flagellin-Mediated Immune Recognition. Infect. Immun. 2016, 84, 162–171. [Google Scholar] [CrossRef]
- Caiazza, N.C.; Shanks, R.M.Q.; O’toole, G.A. Rhamnolipids Modulate Swarming Motility Patterns of Pseudomonas aeruginosa. J. Bacteriol. 2005, 187, 7351–7361. [Google Scholar] [CrossRef]
- Mun, I.R.A.; Hussin, M.S.; Kadum, M.M. Study of Prodigiosin and Virulence Factor Producing by Multi Drug Resistance Serratia marcescens Isolated from Some of Baghdad Hospitals Environment. Al-Mustansiriyah J. Sci. 2008, 19, 1–9. [Google Scholar]
- De La Fuente-Núñez, C.; Korolik, V.; Bains, M.; Nguyen, U.; Breidenstein, E.B.M.; Horsman, S.; Lewenza, S.; Burrows, L.; Hancock, R.E.W. Inhibition of Bacterial Biofilm Formation and Swarming Motility by a Small Synthetic Cationic Peptide. Antimicrob. Agents Chemother. 2012, 56, 2696–2704. [Google Scholar] [CrossRef] [PubMed]
- Lin, Y.; Chen, J.; Zhou, X.; Li, Y. Inhibition of Streptococcus mutans Biofilm Formation by Strategies Targeting the Metabolism of Exopolysaccharides. Crit. Rev. Microbiol. 2021, 47, 667–677. [Google Scholar] [CrossRef] [PubMed]

Disclaimer/Publisher’s Note: The statements, opinions and data contained in all publications are solely those of the individual author(s) and contributor(s) and not of MDPI and/or the editor(s). MDPI and/or the editor(s) disclaim responsibility for any injury to people or property resulting from any ideas, methods, instructions or products referred to in the content. |
© 2023 by the authors. Licensee MDPI, Basel, Switzerland. This article is an open access article distributed under the terms and conditions of the Creative Commons Attribution (CC BY) license (https://creativecommons.org/licenses/by/4.0/).
Share and Cite
Awadelkareem, A.M.; Siddiqui, A.J.; Noumi, E.; Ashraf, S.A.; Hadi, S.; Snoussi, M.; Badraoui, R.; Bardakci, F.; Ashraf, M.S.; Danciu, C.; et al. Biosynthesized Silver Nanoparticles Derived from Probiotic Lactobacillus rhamnosus (AgNPs-LR) Targeting Biofilm Formation and Quorum Sensing-Mediated Virulence Factors. Antibiotics 2023, 12, 986. https://doi.org/10.3390/antibiotics12060986
Awadelkareem AM, Siddiqui AJ, Noumi E, Ashraf SA, Hadi S, Snoussi M, Badraoui R, Bardakci F, Ashraf MS, Danciu C, et al. Biosynthesized Silver Nanoparticles Derived from Probiotic Lactobacillus rhamnosus (AgNPs-LR) Targeting Biofilm Formation and Quorum Sensing-Mediated Virulence Factors. Antibiotics. 2023; 12(6):986. https://doi.org/10.3390/antibiotics12060986
Chicago/Turabian StyleAwadelkareem, Amir Mahgoub, Arif Jamal Siddiqui, Emira Noumi, Syed Amir Ashraf, Sibte Hadi, Mejdi Snoussi, Riadh Badraoui, Fevzi Bardakci, Mohammad Saquib Ashraf, Corina Danciu, and et al. 2023. "Biosynthesized Silver Nanoparticles Derived from Probiotic Lactobacillus rhamnosus (AgNPs-LR) Targeting Biofilm Formation and Quorum Sensing-Mediated Virulence Factors" Antibiotics 12, no. 6: 986. https://doi.org/10.3390/antibiotics12060986










